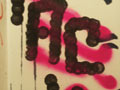

die bilder vom
klo (13. september 2007 - 31. januar 2008)
die bilder vom
klo (13. september 2007 - 31. januar 2008)




























































































































































































































































































































































































































![]()
 die bilder vom
klo (13. september 2007 - 31. januar 2008)
die bilder vom
klo (13. september 2007 - 31. januar 2008)

070527 47 47 |
070609 42 42 |
070619
 24 24 |
070711 12 12 |
070716 102 102 |
070913 413
fotos 413
fotos |
![]()
![]()
![]()
![]()
![]()
alle rechte bei den urhebern